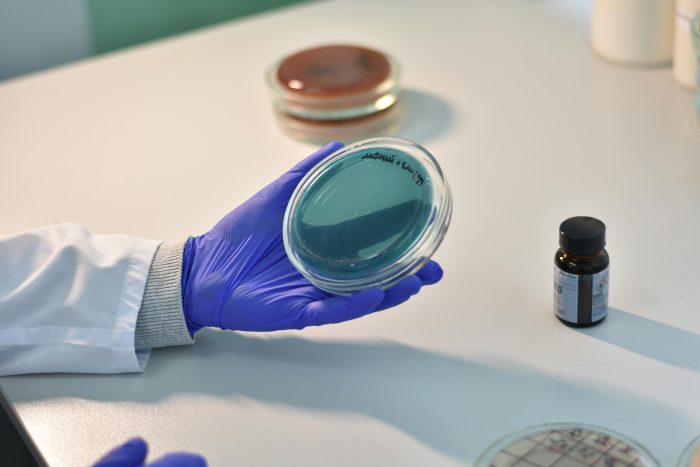

*Por Luiz Alexandre Combat

Reina na comunidade científica contemporânea um dogma silencioso: qualquer explicação não materialista para fenômenos observáveis é descartada de imediato como misticismo. Pesquisadores que ousam mencionar a possibilidade de design inteligente são ridicularizados como ingênuos, curiosamente, pelos mesmos cientistas que reconhecem instantaneamente a ação de uma mente ao analisar hieróglifos egípcios, códigos antigos ou qualquer forma de linguagem organizada.
Mas, quando o assunto é a vida na Terra, esse mesmo padrão de racionalidade desaparece. A ciência dominante rejeita, a priori, qualquer hipótese que atribua a uma inteligência a origem da informação biológica contida no DNA. Rejeita sem sequer admitir investigação séria, não por falta de evidências, mas por mero preconceito filosófico.

Tal postura trai o próprio espírito científico, que exige examinar hipóteses antes de descartá-las. E expõe algo ainda mais humano: vaidade. Uma recusa obstinada em admitir que a biologia moderna já produziu evidências amplas, consistentes e definitivas de que a vida é fruto de intenção.
De fato, não há um único sistema conhecido na natureza em que informação codificada, como a contida no DNA, surja sem uma mente por trás. Jamais ocorreu em observação natural. Jamais vai ocorrer. E não poderia ser diferente: causas materiais não criam efeitos imateriais como estabelecimento de símbolos, semântica e atribuição arbitrária de significados, elementos indispensáveis a qualquer linguagem.
Ainda assim, o materialismo insiste em defender que o maior, mais complexo e mais perfeito sistema informacional já descoberto, o DNA, tenha emergido por acaso.
Quando Watson e Crick decifraram o código genético em 1953, eles, sem se darem conta, implodiram o paradigma materialista da biologia moderna e demonstraram, de forma inequívoca, o caráter criacionista da vida. Uma vez revelado que símbolos e significados regem os processos vitais, não há mais como sustentar a ficção de que estruturas de informação funcional, baseadas em regras arbitrárias e dependentes de estabilidade semântica, tenham surgido por processos cegos.
A biologia não descobriu uma molécula. Descobriu o Código de Deus — a linguagem computacional, o software, o app que programa a vida para funcionar, gerar energia e até criar e reparar o próprio hardware. Atribuir tal estrutura a processos cegos é equivalente a afirmar que a pedra de Roseta se escreveu sozinha — erosão criativa, vento alfabetizado, areia linguista.
A verdade é simples e luminosa: A vida carrega a assinatura de uma inteligência criadora. A ciência é criacionista. O que falta não é evidência — é coragem, em especial para encarar as implicações desse fato.
Luiz Alexandre Combat é formado em Teologia, pesquisador e autor do livro “Negacionista é o ateu! Como a genética prova que Deus está literalmente dentro de nós”





